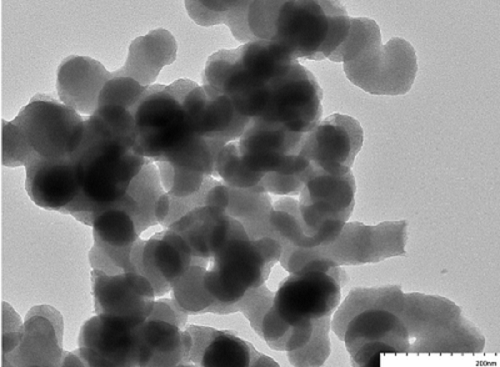
洋葱碳 纳米洋葱碳

洋葱碳 纳米洋葱碳
Onion-like Carbon
¥300
1g
起订
¥1200
5g
起订
¥25000
1000g
起订
江苏 更新日期:2024-01-24
产品详情:
- 中文名称:
- 洋葱碳
- 英文名称:
- Onion-like Carbon
- 品牌:
- 清碳纳米
- 产地:
- 苏州
- 产品类别:
- 纳米碳材料
公司简介
苏州清碳纳米材料有限公司位于昆山开发区,创始团队来自清华大学化学系,是一家专业从事纳米多孔碳材料的高科技企业。清碳纳米拥有专业的研发团队与完善的实验设施,并且与清华大学、西湖大学、中科院青岛能源所等高校科研团队建立了深度合作,形成了针对1-1000nm范围内的孔径调节技术和表面修饰技术体系,为抗乙醇干扰甲烷传感器、气相色谱、吸附制冷、药物载体、氢燃料电池、电解水等多个领域提供了纳米多孔碳材料。
| 成立日期 | (4年) |
| 注册资本 | 600 |
| 员工人数 | 1-10人 |
| 年营业额 | ¥ 100万以内 |
| 经营模式 | 工厂,试剂,定制 |
| 主营行业 | 纳米材料,催化剂,基础无机试剂 |